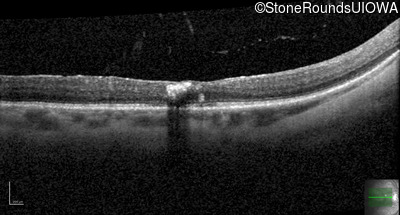
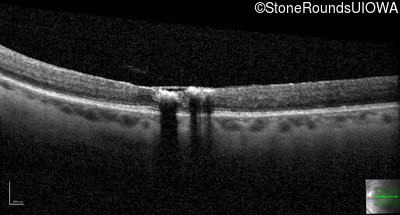
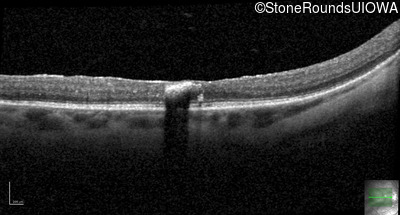
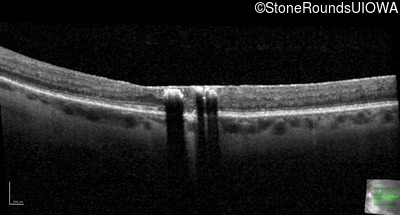
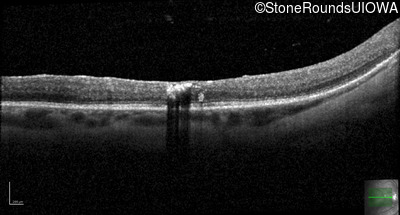
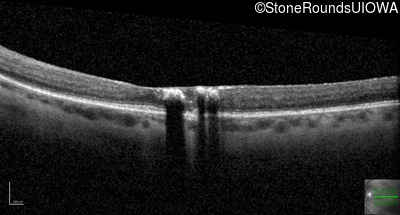

Case
SR2851
Student Mode
Autosomal Dominant Vitreoretinochoroidopathy (III4A)
Female
Female
Hidden
SR2851
Student Mode
Autosomal Dominant Vitreoretinochoroidopathy (III4A)
Female
Female
History
This 47 year old woman began wearing glasses at age 5 and had cataract surgery at age 32. At that time her doctor noticed a retinal abnormality.
| Age at visit: 47 years |
| Age at visit: 49 years |
| Age at visit: 50 years |
| OD | OS | ||
|---|---|---|---|
| Age at visit: 51 years |
| OD | OS | ||
|---|---|---|---|
| OD | OS | ||
|---|---|---|---|
| OD | OS | ||
|---|---|---|---|
Diagnosis & molecular findings
| Disease | Gene | Allele 1 variant(s) | Allele 2 variant(s) | Inheritance mode |
|---|---|---|---|---|
| Autosomal Dominant Vitreoretinochoroidopathy | BEST1 | Tyr72Asn TAC>AAC | AD |
Gene:
Allele 1:
Tyr72Asn TAC>AAC
Allele 2:
Inheritance:
AD